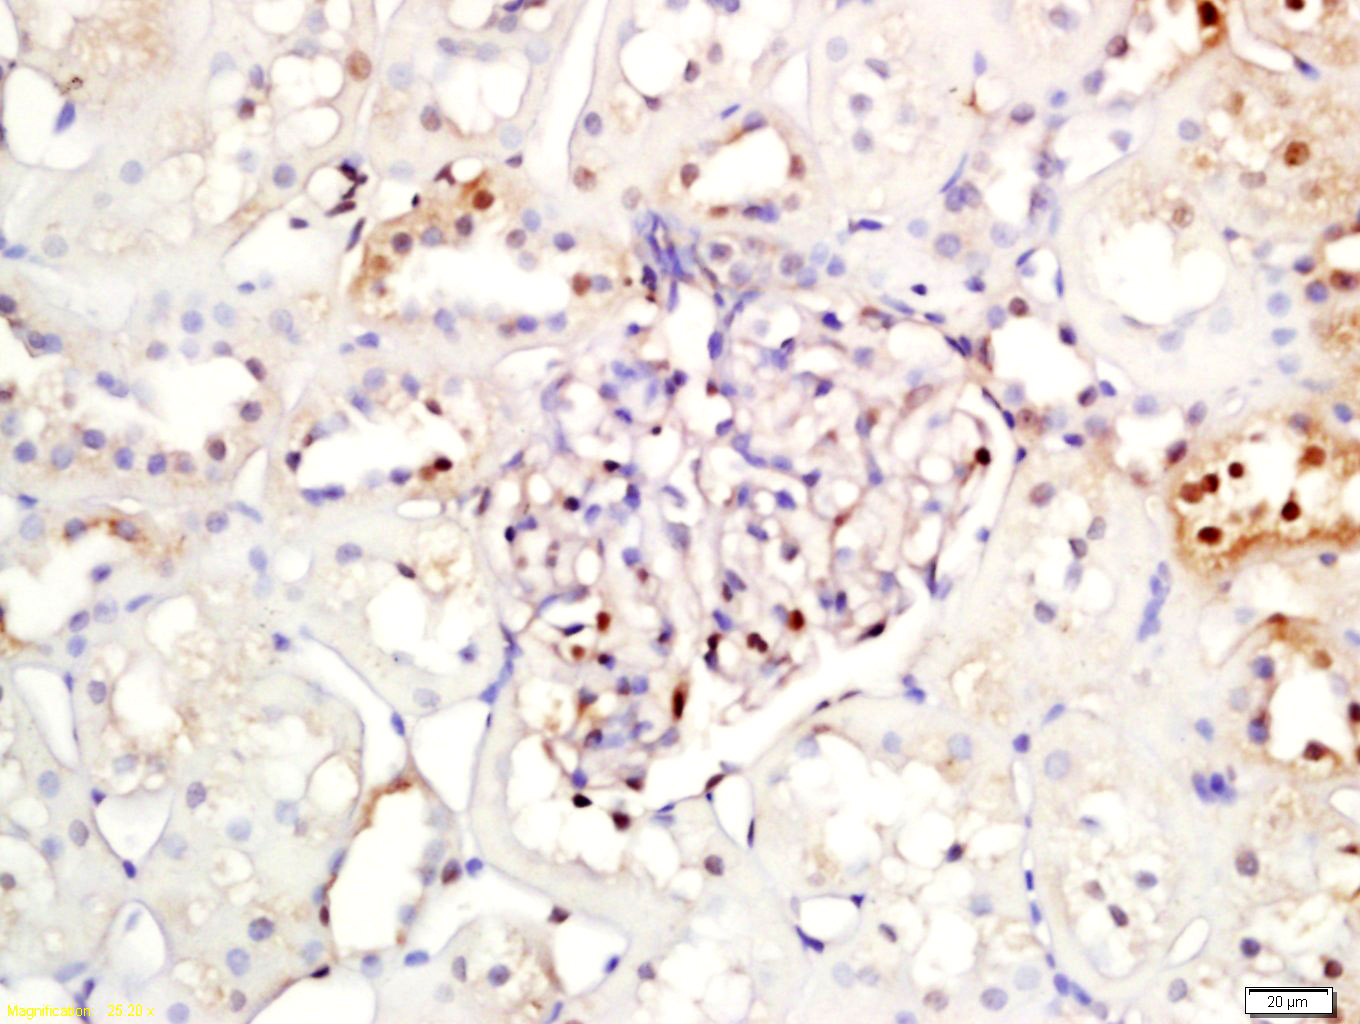
核因子κB抑制蛋白α抗体-bs-1287R
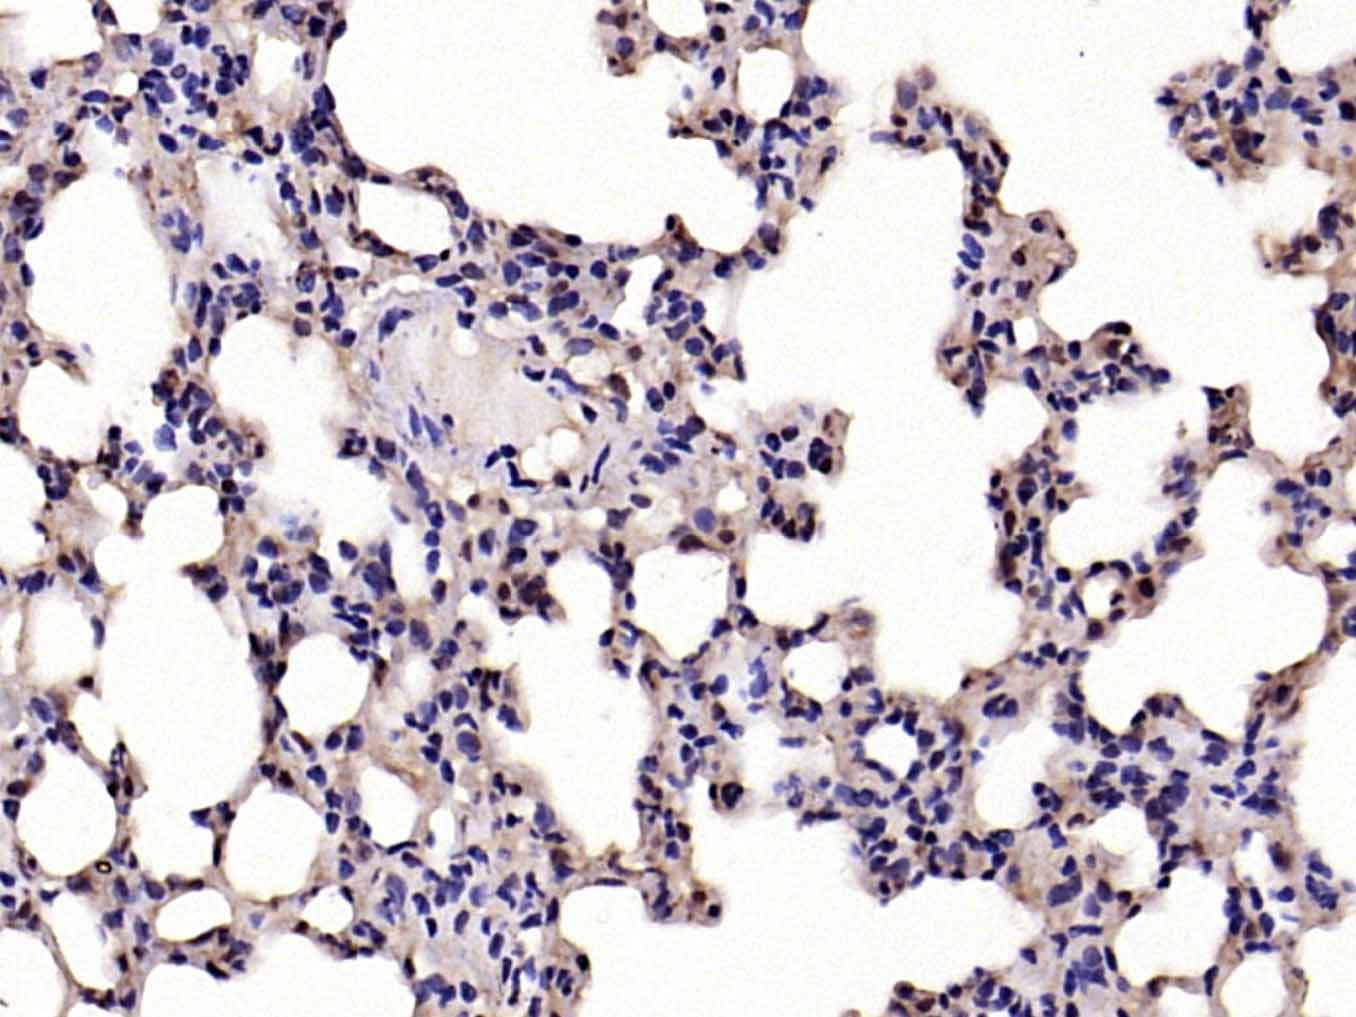
核因子κB抑制蛋白α抗体-bs-1287R

IKB alpha Rabbit pAb (一抗) - WB,IHC-P,IHC-F,IF,Flow-Cyt,ICC/IF | Bioss

货号:bs-1287R
产品详情
相关标记
相关产品
相关文献
常见问题
概述
产品编号
bs-1287R
英文名称
IKB alpha Rabbit pAb
中文名称
核因子κB抑制蛋白α抗体
英文别名
EDAID2; IKBA; MAD-3; NFKBI; IKBA_HUMAN; NFKBIA; I-kappa-B-alpha (IkB-alpha | IkappaBalpha); Major histocompatibility complex enhancer-binding protein MAD3; MAD3; NFKB inhibitor alpha; nuclear factor of kappa light polypeptide gene enhancer in B-cells inhibitor, alpha; NF-kappa-B inhibitor alpha
抗体来源
Rabbit
免疫原
KLH conjugated synthetic peptide derived from human NFKBIA: 1-120/314
亚型
IgG
性状
Liquid
纯化方法
affinity purified by Protein A
克隆类型
Polyclonal
理论分子量
36 kDa
检测分子量
38 kDa
浓度
1mg/ml
储存液
0.01M TBS (pH7.4) with 1% BSA, 0.02% Proclin300 and 50% Glycerol.
研究领域
SWISS
Gene ID
保存条件
Shipped at 4℃. Store at -20℃ for one year. Avoid repeated freeze/thaw cycles.
注意事项
This product as supplied is intended for research use only, not for use in human, therapeutic or diagnostic applications.
产品介绍
转录调节因子(Transcriptin Regulators)
背景资料
This gene encodes a member of the NF-kappa-B inhibitor family, which contain multiple ankrin repeat domains. The encoded protein interacts with REL dimers to inhibit NF-kappa-B/REL complexes which are involved in inflammatory responses. The encoded protein moves between the cytoplasm and the nucleus via a nuclear localization signal and CRM1-mediated nuclear export. Mutations in this gene have been found in ectodermal dysplasia anhidrotic with T-cell immunodeficiency autosomal dominant disease. [provided by RefSeq, Aug 2011]

产品应用
| 应用 | 已检合格种属 | 预测种属 | 推荐稀释比例 |
|---|---|---|---|
| WB | Mouse, Rat | Human | 1:500-2000 |
| IHC-P | Mouse, Rat | Human | 1:100-500 |
| IHC-F | Mouse, Rat | Human | 1:100-500 |
| IF | Mouse, Rat | Human | 1:100-500 |
| Flow-Cyt | Human | Mouse, Rat | 1μg/Test |
| ICC/IF | Human | Mouse, Rat | 1:100-500 |
交叉反应
交叉反应: Human, Mouse, Rat
相关产品
暂无相关产品
靶标
基因名
NFKBIA
蛋白名
NF-kappa-B inhibitor alpha
亚基
Interacts with RELA; the interaction requires the nuclear import signal. Interacts with NKIRAS1 and NKIRAS2. Part of a 70-90 kDa complex at least consisting of CHUK, IKBKB, NFKBIA, RELA, IKBKAP and MAP3K14. Interacts with HBV protein X. Interacts with RWDD3; the interaction enhances sumoylation. Interacts (when phosphorylated at the 2 serine residues in the destruction motif D-S-G-X(2,3,4)-S) with BTRC. Associates with the SCF(BTRC) complex, composed of SKP1, CUL1 and BTRC; the association is mediated via interaction with BTRC. Part of a SCF(BTRC)-like complex lacking CUL1, which is associated with RELA; RELA interacts directly with NFKBIA. Interacts with PRMT2. Interacts with PRKACA in platelets; this interaction is disrupted by thrombin and collagen. Interacts with HIF1AN.
亚细胞定位
Cytoplasm. Nucleus. Shuttles between the nucleus and the cytoplasm by a nuclear localization signal (NLS) and a CRM1-dependent nuclear export.
组织特异性
Highly expressed in lymph node, thymus followed by liver, brain, muscle, kidney, gastrointestinal and reproductive tract.
翻译后修饰
Phosphorylated; disables inhibition of NF-kappa-B DNA-binding activity. Phosphorylation at positions 32 and 36 is prerequisite to recognition by UBE2D3 leading to polyubiquitination and subsequent degradation.
Sumoylated; sumoylation requires the presence of the nuclear import signal.
Monoubiquitinated at Lys-21 and/or Lys-22 by UBE2D3. Ubiquitin chain elongation is then performed by CDC34 in cooperation with the SCF(FBXW11) E3 ligase complex, building ubiquitin chains from the UBE2D3-primed NFKBIA-linked ubiquitin. The resulting polyubiquitination leads to protein degradation. Also ubiquitinated by SCF(BTRC) following stimulus-dependent phosphorylation at Ser-32 and Ser-36.
Deubiquitinated by porcine reproductive and respiratory syndrome virus Nsp2 protein, which thereby interferes with NFKBIA degradation and impairs subsequent NF-kappa-B activation.
Deubiquitinated by porcine reproductive and respiratory syndrome virus Nsp2 protein, which thereby interferes with NFKBIA degradation and impairs subsequent NF-kappa-B activation.
疾病
Defects in NFKBIA are the cause of ectodermal dysplasia anhidrotic with T-cell immunodeficiency autosomal dominant (ADEDAID) [MIM:612132]. Ectodermal dysplasia defines a heterogeneous group of disorders due to abnormal development of two or more ectodermal structures. ADEDAID is an ectodermal dysplasia associated with decreased production of pro-inflammatory cytokines and certain interferons, rendering patients susceptible to infection.
相似性
Belongs to the NF-kappa-B inhibitor family.
Contains 5 ANK repeats.
Contains 5 ANK repeats.
功能
Inhibits the activity of dimeric NF-kappa-B/REL complexes by trapping REL dimers in the cytoplasm through masking of their nuclear localization signals. On cellular stimulation by immune and proinflammatory responses, becomes phosphorylated promoting ubiquitination and degradation, enabling the dimeric RELA to translocate to the nucleus and activate transcription.
同靶标产品
相关文献
提示: 发表研究结果有使用 bs-1287R 时请让我们知道,以便我们可以引用参考文章。作为回馈,资料提供者将获得我们送上的小礼品。
具体参考文献:bs-1287R 被引用于124文献中